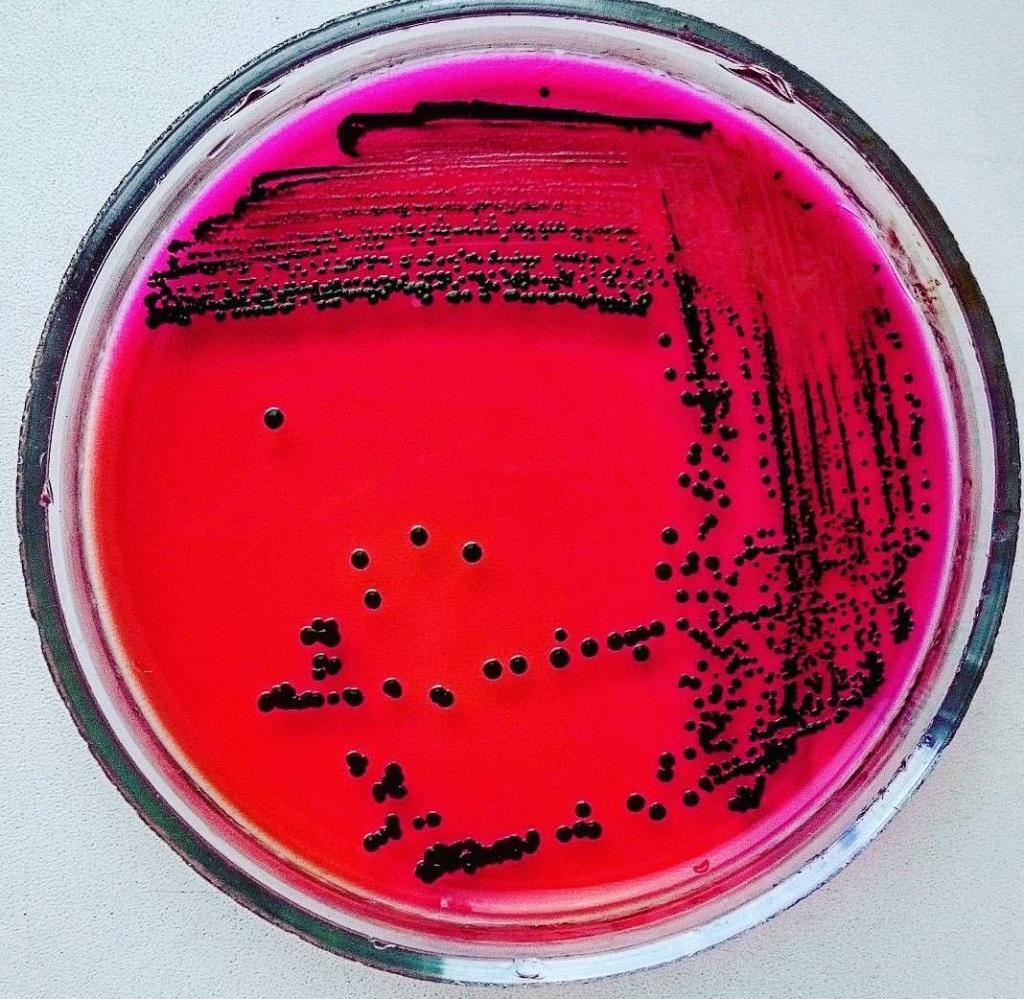
image

Сальмонеллез — инфекционное заболевание, вызываемое бактериями рода Salmonella, передающееся через сырые или недостаточно обработанные продукты, включая яйца. В последние годы случаи сальмонеллеза, связанные с сырыми яйцами, привлекли внимание медицинских специалистов и потребителей. Эта статья информирует о рисках употребления сырых яиц и предлагает рекомендации по безопасному обращению с продуктами для минимизации вероятности заражения и защиты здоровья.
Бывает ли в перепелиных яйцах сальмонелла?
Долгое время существовало мнение, что ответ на этот вопрос отрицательный. Это объяснялось тем, что температура тела птиц может достигать 44 °С, что является неблагоприятной средой для бактерий. Существовало общее убеждение, что птицы не подвержены воздействию данной бактерии.
Тем не менее, эти предположения были опровергнуты в ходе научных исследований. Ответ на вопрос о наличии сальмонеллы в перепелиных яйцах — “да”. К сожалению, это так.
Почему же бактерия может оказаться в яйцах перепелок? Чаще всего это происходит из-за использования корма низкого качества, содержащего микроорганизмы. Кроме того, несоблюдение норм содержания птиц, а также неподходящие условия окружающей среды могут ослабить иммунитет перепелов, что способствует развитию сальмонеллеза.
Сальмонеллез, вызванный бактериями рода Salmonella, представляет собой серьезную угрозу для здоровья человека, особенно в контексте потребления сырых яиц. Эксперты подчеркивают, что яйца могут быть заражены сальмонеллой как на этапе производства, так и в процессе хранения. Риск возрастает, если яйца не подвергаются термической обработке. Исследования показывают, что даже небольшое количество бактерий может вызвать инфекцию, проявляющуюся симптомами гастроэнтерита. Профилактика заключается в соблюдении правил хранения и приготовления яиц, а также в выборе продуктов от проверенных производителей. Специалисты рекомендуют избегать употребления сырых яиц, особенно для уязвимых групп населения, таких как дети, пожилые люди и беременные женщины.

Сальмонеллез — что за “зверь”?
Сальмонелла — палочковидная неспороносная бактерия. Провоцирует острое инфекционное заболевание сальмонеллез, которым могут заразиться как животные, так и человек. Поражает органы пищеварительной системы.
Бактерия сальмонелла попадает в организм через такие продукты, как яйца, молоко и молочные продукты, мясо, которые не подверглись термической обработке. Именно высокая температура губительна для бактерии.
Жизнеспособность анаэробов в воде сохраняется до 5 месяцев, а вот в почве до полутора лет. Сырое мясо “хранит” в себе палочковидную бактерию до полугода. Что касается молочки, то здесь продолжительность жизни сальмонеллы следующие:
- примерно 20 дней в молоке;
- 30 дней в кефире;
- 4-5 дней в сливочном масле;
- в сыре бактерия живет до года.
В яичном продукте жизнеспособность тоже имеет свой срок:
- 3-9 месяцев в яичном порошке;
- 17-24 дня на скорлупе.
Сальмонеллы гибнут при температуре 70 °С, то есть примерно на 7 минуте варки. Однако если варится крупный кусок мяса, то в его толще бактерии выдерживают 10-20 минут кипячения.
Сколько времени варить перепелиные яйца, чтобы уничтожить бактерию? 4-5 минут будет достаточно для истребления сальмонеллы. Этого же времени достаточно и для куриных яиц.
В молоке и мясных продуктах сальмонеллы не только долго сохраняются, но и интенсивно размножаются. При этом, микроорганизмы хорошо переносят процесс продуктового соления и копчения, а вот при заморозке даже продлевают свою жизнеспособность.
| Симптом | Описание | Время появления симптомов |
|---|---|---|
| Диарея | Частый, водянистый стул, иногда с кровью или слизью | 6-72 часа после заражения |
| Лихорадка | Повышение температуры тела | 6-72 часа после заражения |
| Рвота | Выбрасывание содержимого желудка | 6-72 часа после заражения |
| Спазмы в животе | Сильные боли в животе | 6-72 часа после заражения |
| Головная боль | Боль в голове | Может появиться, но не всегда |
| Слабость | Общее недомогание, усталость | Может появиться, но не всегда |
| Мышечные боли | Боль в мышцах | Может появиться, но не всегда |
Интересные факты
Вот несколько интересных фактов о сальмонеллезе и сырых яйцах:
-
Источники инфекции: Сальмонелла может находиться не только на поверхности яиц, но и внутри них. Это происходит, когда бактерии проникают в яйцо через поры в скорлупе или даже во время формирования яйца в организме курицы. Поэтому даже яйца с неповрежденной скорлупой могут быть заражены.
-
Температурный режим: Сальмонелла может размножаться при температуре от 7 до 48 градусов Цельсия, но наиболее активно она размножается при температуре около 37 градусов. Это подчеркивает важность хранения яиц в холодильнике, чтобы замедлить рост бактерий.
-
Риск для здоровья: По данным Центров по контролю и профилактике заболеваний (CDC), в США сальмонеллез, связанный с сырыми или недоваренными яйцами, приводит к примерно 79 000 случаям заболевания и 30 смертям ежегодно. Это делает сырые яйца потенциально опасным продуктом, особенно для уязвимых групп населения, таких как дети, пожилые люди и люди с ослабленной иммунной системой.

Последствия для человека
Любители яиц, особенно перепелиных, могут не отказывать себе в этом любимом продукте из-за страха заразиться неприятной болезнью. Дело в том, что бактерия сальмонелла обитает исключительно на поверхности яичной скорлупы, но в течение суток-пяти может проникнуть внутрь яйца при определенных условиях.
Поэтому важно соблюдать меры предосторожности перед тем, как употреблять яйца. Рекомендуется тщательно мыть скорлупу с мылом или моющим средством перед тем, как разбить яйцо.
Существует несколько заболеваний, вызванных сальмонеллами, и одно из них, которое встречается у птиц, называется пуллороз. Интересно, что бактерия Salmonella gallinarum, вызывающая пуллороз у перепелок, у человека приводит лишь к легкой форме пищевого отравления. В то же время, Salmonella enteritidis не представляет опасности для птиц, но может быть смертельно опасна для человека, иногда даже приводя к летальному исходу.
Симптомы сальмонеллеза у человека включают повышенную температуру, диарею, слабость и мышечные боли. Поэтому при появлении этих признаков необходимо незамедлительно обратиться к врачу.
Миф о перепелиных яйцах
Долгое время компании по поставке на прилавки изучаемого товара утверждали, что их продукт абсолютно безопасен даже в сыром виде. Даже японские ученые проводили эксперимент, в котором люди пили сырой продукт и их состояние улучшалось: нормализовывалось пищеварение, проходили головные боли, исчезала утомляемость. И никакой сальмонеллез их не атаковал.
Однако все бы это можно было принять за реальность, если бы не одно “но”. Помимо питья сырых яиц испытуемые ели овощи, злаки, отказались от вредной жареной и копченой пищи. Что уже, само по себе, нормализует состояние здоровья.
Почему в перепелиных яйцах нет сальмонеллы, а именно в тех, что шли в пищу испытуемым? Вероятно, качество продукта было высокого уровня, исключающее развитие бактерии на поверхности.
Причины появления мифа
Существует ли сальмонелла в перепелиных яйцах? Ответ на этот вопрос положительный. Миф о полном отсутствии этого микроорганизма в данном продукте возник из-за того, что температура тела перепелов выше, чем у кур или гусей. Это создает условия, при которых бактерия не может развиваться и погибает.
Хотя сами перепела не страдают от сальмонеллеза, бактерия может находиться в их организме в состоянии анабиоза, не оказывая негативного влияния на здоровье птиц. На самом деле, только высокая температура, достигающая 70 градусов, способна уничтожить сальмонеллу, но лишь при условии, что она будет поддерживаться в течение нескольких минут. Поэтому важно знать, как долго нужно варить перепелиные яйца, чтобы избежать риска.
Таким образом, можно утверждать, что перепела и их яйца могут быть потенциальными носителями сальмонеллы.
О чем вещают маркировки на упаковках с яйцами перепелов?
Миф о том, что перепелки не болеют сальмонеллезом и их яйца можно пить в сыром виде, некоторое время был напечатан на упаковках с продуктом. И претензий к этой надписи, с юридической точки зрения, нет. Ведь действительно птицы не болеют сальмонеллезом, они лишь являются его переносчиком. А этот факт не оглашался нигде.
Хотя немалое количество потребителей согласились с отсутствием вреда от перепелиных яиц, ведь случаев заражения известно не так уж и много. Но это обусловлено тем, что куриные яйца используются в пищу чаще, чем перепелиные, а значит риск заразиться от куриных во много раз выше.
Сырые яйца перепелов: последствия
В заключение можно отметить, что употребление сырых яиц или яиц с немытыми скорлупами может привести к возникновению у человека следующих симптомов:
- повышение температуры тела;
- нарушения в работе пищеварительной системы, проявляющиеся в виде тошноты, рвоты и/или диареи;
- аллергические реакции на коже, особенно часто встречающиеся у детей;
- резкая боль в области живота.
Симптомы заражения могут проявиться через 2-3 часа после контакта, хотя инкубационный период может продолжаться до 3 суток в организме человека.
Профилактические меры
Важно соблюдать следующие рекомендации:
- Перед использованием перепелиных яиц их скорлупу вымыть с мылом и щеткой.
- Варить не менее 10 минут, поэтому от яиц “в мешочках” стоит отказаться.
- Любителям омлета нужно обжаривать блюдо с двух сторон, подвергнув его полной термической обработке.
- От такого блюда, как глазунья, стоит и вовсе отказаться, особенно любителям жидкого желтка.
- Перед покупкой проверять срок годности яиц, а дома провести дополнительные проверочные мероприятия.
- Мыть регулярно руки, особенно после контакта с яйцами в скорлупе.
- При первых симптомах, которые могут свидетельствовать о сальмонеллезе, обращаться к врачу.
Как проверить продукт на наличие бактерии?
Отказываться от употребления перепелиных яиц не стоит, так как они приносят значительную пользу организму. Кроме того, существует возможность проверить их качество, но это можно сделать только в лабораторных условиях, где результаты будут абсолютно точными.
При покупке яиц в магазине или на рынке важно обратить внимание на срок годности, так как риск заражения инфекцией от свежих яиц крайне низок, практически равен нулю. Согласно ГОСТу, перепелиные яйца могут храниться при температуре от 0 до 25° в течение 25 дней.
Проверить свежесть яиц можно и в домашних условиях. Один из популярных методов заключается в том, чтобы опустить яйца в емкость с холодной водой. Свежие яйца останутся на дне, яйца, которые не первой свежести, встанут вертикально — тупым концом вверх, а испорченные яйца всплывут на поверхность.
Еще один способ определить свежесть перепелиных (как и любых других) яиц — это разбить их в миску и оценить состояние желтка. Если желток выглядит размазанным и не однородным, это свидетельствует о том, что яйцо не первой свежести.
Заключение
Есть ли сальмонелла в перепелиных яйцах — уже давно решенный вопрос. Как и аналогичная продукция от кур или гусей, эти несут такой же риск заражения. Но меры предосторожности помогут не заболеть сальмонеллезом. А от употребления продукта в сыром виде и вовсе стоит отказаться.
Можно ли убить себя куриными яйцами? Оказывается, вполне можно – в привычном для каждой хозяйки продукте живет микроб сальмонелла энтерика. Согласно статистике сальмонеллез занимает ведущее место по численности летальных случаев, вызванных пищевыми отравлениями.
Бактерия особенно страшна для детей, людей в старческом возрасте и лиц со слабым иммунитетом. Да и крепких людей с каждым годом излечивать становится труднее – сальмонеллы потеряли чувствительность к целому ряду антибиотиков. Поэтому надо помнить об опасности, когда вам захочется съесть куриное яйцо.
Где находится возбудитель?
Сальмонелла обитает в кишечнике домашних птиц, таких как куры, утки и гуси. Однако, поскольку гусей и уток употребляют в пищу реже, основным источником заражения являются хохлатые несушки.
Примерно 25% куриц и около 70% уток и гусей среди домашней птицы заражены сальмонеллой. При этом сами птицы не проявляют признаков болезни, выступая в роли носителей этого микроорганизма.
Сальмонелла может находиться как в яйцах, так и в мясе птицы. Яйцо покрыто пористой известковой скорлупой, которая, проходя через клоаку, загрязняется множеством микроорганизмов, включая сальмонеллу.
Заражение яиц может происходить не только снаружи, но и изнутри. Сальмонелла проникает через скорлупу и, попадая в белок, начинает активно размножаться.
Как передается инфекция?
Летом сырые продукты всегда представляют опасность. Но яйца с сальмонеллой могут быть опасны не только летом, но и самой суровой зимой.
Сколько продукт ни охлаждай, бактерия не погибнет – в холодильнике она может жить и размножаться до 12 месяцев. Съев сырой продукт, приготовив на основе белка крем для тортика, человек рискует получить патогенную сальмонеллу.
Но это воплотится в будущем. Сегодня сальмонелла является опаснейшей бактерией, от которой можно погибнуть, и которую практически невозможно обнаружить по каким-нибудь признакам на продукте – зараженное мясо или яйцо может не пахнуть и не изменяться.
Главная опасность в том, что сальмонелла поражает соседствующие с вредными яйцами продукты и стенки холодильника.
Человек может заразиться сальмонеллезом в местах общепита, где не всегда соблюдаются санитарные нормы и яйца закупаются подешевле у недобросовестных поставщиков.
Яйца могут быть битыми и не прошедшими санитарную обработку. Из них готовятся всевозможные десерты, блюда, выпечка, и люди рискуют подхватить сальмонеллу, просто съев порцию мороженого жарким днем.
Бывает ли сальмонеллез в перепелиных яйцах?
У перепелов температура тела значительно выше, чем у кур — достигает 40 градусов. Именно поэтому сальмонелла в перепелином мясе практически не выживает, так как ей сложно размножаться в таких условиях. Даже если бактерии и присутствуют, они не смогут попасть в яйцо, поскольку тонкая и хрупкая скорлупа перепелиных яиц обладает гораздо меньшими порами по сравнению с куриными.
Тем, кто любит гоголи-моголи, глазунью или кремы, стоит обратить внимание на перепелиные яйца. Они более полезны, чем куриные, так как содержат в три раза больше витаминов и микроэлементов. Перепелиные яйца также рекомендуются для маленьких детей благодаря своей гипоаллергенности.
Как проверить продукт на наличие инфекции?
Обнаружить сальмонеллу в продукте можно только в лабораторных условиях. Но риск подхватить бактерию гораздо ниже, если купленные яйца будут свежими. Срок их годности при температуре хранения 0-25 градусов составляет, согласно ГОСТ, 25 дней со дня сортировки.
Закупленные на стихийном рынке яйца маркировки не имеют, но их свежесть можно проверить простым способом – опустить в емкость с холодной водой. Несвежие перевернуться, и приподнимутся тупым концом вверх, совсем старые могут даже всплыть.
Если, разбив яйцо, вы видите, что желток сильно размазан, потерял форму и расплылся в белке, то есть вероятность, что оно давно снесено.
Профилактические меры против заражения
Кипячение и обжарка при температуре выше 70 градусов способны уничтожить бактерии. При 100 градусах они погибают всего за 3 минуты. Поэтому не стоит рисковать и наслаждаться яйцами «в мешочек» или яичницей-глазуньей.
Для яиц важно, чтобы термическая обработка длилась не менее 10-15 минут после закипания воды. При приготовлении яичницы не следует пробовать блюдо, если оно еще не прожарено, или облизывать лопатку.
Следует также придерживаться других мер предосторожности:
- Используйте отдельную доску и нож для нарезки сырых продуктов;
- Храните сырые и готовые продукты на разных полках в холодильнике;
- Варите куриное мясо не менее 1,5 часов;
- Обязательно кипятите цельное молоко;
- Перед использованием яйца необходимо мыть с моющим средством.
Видео о том, как проверить яйца на свежесть и защититься от сальмонеллеза:

- Покупайте яйца только в магазинах, в упаковках от проверенных производителей. В супермаркетах яйца поступают с птицефабрик, где осуществляется санитарный контроль и проверка на инфекции.
- Лучше избегать покупок на рынках, так как неизвестно, от каких куриц эти яйца.
- Яйца должны быть целыми, не окрашенными кровью или с большим количеством помета.
- Чем свежее, тем лучше.
- Перед употреблением и приготовлением яйца следует тщательно мыть с мылом.
- Также не забывайте о простом мытье рук перед едой.
Рекомендуется отказаться от блюд с сырыми яйцами для больных, детей до 3-5 лет, а также для беременных и кормящих женщин.
Когда вы будете уверены в безопасности, советую попробовать приготовить классическую пасту карбонара. Именно сырые яйца в этом рецепте придают соусу кремовую текстуру без добавления сливок.
Рекомендации по приготовлению яиц для минимизации риска
Сальмонеллез, вызванный бактериями рода Salmonella, является серьезной проблемой, связанной с потреблением сырых или недостаточно приготовленных яиц. Чтобы минимизировать риск заражения, важно следовать нескольким рекомендациям по безопасному приготовлению и употреблению яиц.
1. Выбор яиц: При покупке яиц следует обращать внимание на их свежесть и целостность. Яйца должны быть без трещин и повреждений, так как это может быть входной точкой для бактерий. Рекомендуется приобретать яйца от проверенных производителей, которые соблюдают санитарные нормы. Также стоит обратить внимание на маркировку: яйца с пометкой «пастеризованные» подвергались специальной обработке, что снижает риск заражения.
2. Хранение яиц: Яйца следует хранить в холодильнике при температуре не выше 4°C. Это помогает замедлить размножение бактерий. Не стоит оставлять яйца при комнатной температуре более двух часов, так как это увеличивает риск роста патогенных микроорганизмов. Также рекомендуется хранить яйца в оригинальной упаковке, чтобы защитить их от загрязнений и запахов других продуктов.
3. Правильное приготовление: Чтобы снизить риск заражения сальмонеллой, яйца необходимо готовить до полной готовности. Это означает, что белок и желток должны быть полностью затвердели. Приготовление яиц всмятку или яиц-пашот, где желток остается жидким, не рекомендуется. Если вы используете яйца в рецептах, требующих сырого продукта (например, в соусах или десертах), стоит рассмотреть возможность использования пастеризованных яиц.
4. Соблюдение гигиенических норм: Перед и после работы с яйцами важно тщательно мыть руки с мылом. Также следует использовать отдельные кухонные принадлежности и посуду для работы с сырыми яйцами, чтобы избежать перекрестного загрязнения. Все поверхности, которые контактировали с сырыми яйцами, необходимо дезинфицировать.
5. Обращение с остатками: Если вы готовите блюда с использованием сырых яиц, такие как майонез или кремы, старайтесь использовать их сразу после приготовления. Оставшиеся продукты следует хранить в холодильнике и употребить в течение 24 часов. Если вы не уверены в безопасности остатков, лучше их выбросить.
Следуя этим рекомендациям, можно значительно снизить риск заражения сальмонеллезом и обеспечить безопасность при употреблении яиц. Помните, что здоровье — это важный аспект, и соблюдение простых правил может помочь избежать серьезных последствий.
Вопрос-ответ
Можно ли заразиться сальмонеллой от сырого яйца?
Считается, что сальмонелла может попасть в организм только с сырыми яйцами и мясом птицы. На самом деле заразиться можно и от домашних животных, вроде попугаев или черепах.
Какая опасность в сырых яйцах?
Чем опасны сырые яйца? Яйца — основной источник заражения человека сальмонеллёзом — острой кишечной инфекцией, причиной которой являются бактерии рода Salmonella. Это опасное заболевание, вызывающее спазмы желудка, диарею, рвоту и даже лихорадку.
Как понять, что в яйце сальмонеллез?
— Обнаружить сальмонеллу в яйце можно только в лабораторных условиях. В нашем учреждении применяются бактериологический и молекулярно-биологический методы диагностики возбудителя сальмонеллеза в биологическом материале, яйцах, продуктах питания, кормах животного и растительного происхождения.
- Яйцо всмятку или глазунья несет такую же опасность, как и сырое яйцо. Источником сальмонеллеза являются куры, а в свежем яйце вредных бактерий нет. Частицы куриного помета, которые содержат сальмонеллу, могут попадать на скорлупу и инфицировать яйцо. Перепелиные яйца тоже могут содержать сальмонеллы.
Советы
СОВЕТ №1
Покупайте яйца только у проверенных производителей. Убедитесь, что яйца имеют целую скорлупу и соответствуют стандартам качества. Обратите внимание на дату упаковки и срок годности.
СОВЕТ №2
Храните яйца в холодильнике при температуре не выше 7°C. Это поможет замедлить размножение бактерий и снизить риск заражения сальмонеллой.
СОВЕТ №3
Избегайте употребления сырых или недоваренных яиц, особенно если у вас ослабленный иммунитет, беременность или маленькие дети. Приготовление яиц до полной готовности убивает потенциальные бактерии.
СОВЕТ №4
Регулярно мойте руки и кухонные принадлежности после работы с сырыми яйцами. Это поможет предотвратить перекрестное загрязнение и снизить риск распространения сальмонеллы.